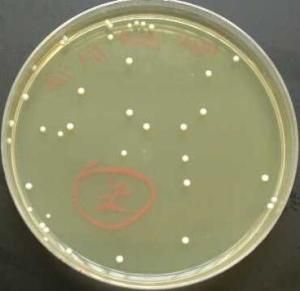
CFU

菌落形成單位
菌落的個數,傳統上叫“個”。但是,一個菌落並不一定是一個細菌所生成,也可能是由一簇細菌(一個細菌團)所生成,因此叫“個”不太準確,準確的叫法是“菌落形成單位”。就像“公斤”和“千克”,只是叫法不同,數量上沒有變化。
cfu/mL指的是每毫升樣品中含有的細菌菌落總數;cfu/g指的是每克樣品中含有的細菌菌落總數;cfu/cm指的是每平方厘米樣品中含有的細菌菌落總數。
平板計數法
CFU法 (colony forming units)即平板計數法,是食品和藥品檢驗中常用的方法。CFU法為將樣品用無菌生理鹽水進行系列稀釋,取合適的稀釋度(一般3個稀釋度),以塗布法接種於平板,或以混碟法進行操作,經過一定時間的培養之後,直接統計平板上的菌落。該方法測定的是樣品中所含的現時可培養的活的微生物數量,所以稱之為活菌計數法。對於那些不可培養的微生物,將不可能統計在內。該方法可以用於樣品中諸如細菌總量、真菌總量、放線菌總量等的定量測定。
活菌計數法中,每個菌落由一個單細胞繁殖而成,為肉眼可見的細胞群體,一般來說在每個平板上形成30~300個菌落屬於有效範圍,該法所測量數值有可能偏低,因為有可能兩個或以上的單細胞在一起形成一個菌落。
——《現代微生物學》科學出版社
CFU